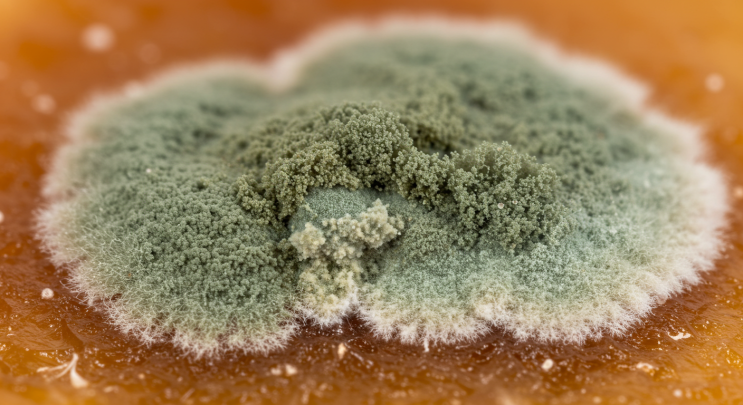

꿀잠 애완 쿠션 by 포즈백 삼각 낮잠 쿠션
2025.08.15

요즘 나랑 한몸, 포즈백 낮잠 쿠션 사실 고3 수험생 선물 주려고 샀다가 한 번 써보고 반해서 애정 아이템...
출처
https://blog.naver.com/dalcom_living/223940317824
이슈모어 핫이슈
-
 최진실 아들 최환희, 스웨덴에서 전한 근황 벤 블리스로 이어가는 음악 인생
최진실 아들 최환희가 스웨덴에서 전한 근황으로 다시 관심을 받고 있다. 어린 시절부터 대중의 시선을 받아온 …
최진실 아들 최환희, 스웨덴에서 전한 근황 벤 블리스로 이어가는 음악 인생
최진실 아들 최환희가 스웨덴에서 전한 근황으로 다시 관심을 받고 있다. 어린 시절부터 대중의 시선을 받아온 …
-
 참교육 윤진 누구길래 시선 집중됐나 김채은, 강렬한 신스틸러로 남긴 존재감
참교육 윤진 캐릭터가 넷플릭스 시리즈 공개 이후 시청자들의 관심을 받고 있다. 강렬한 소재와 빠른 전개로 화…
참교육 윤진 누구길래 시선 집중됐나 김채은, 강렬한 신스틸러로 남긴 존재감
참교육 윤진 캐릭터가 넷플릭스 시리즈 공개 이후 시청자들의 관심을 받고 있다. 강렬한 소재와 빠른 전개로 화…
-
 ITZY 대추 노노 역주행 제대로 터졌다, 콘서트 무대 한 장면이 다시 불러온 중독성 열풍
ITZY 대추 노노 열풍이 온라인에서 확산되며 그룹 ITZY의 무대가 다시 주목받고 있다. 최근 팬들 사이에…
ITZY 대추 노노 역주행 제대로 터졌다, 콘서트 무대 한 장면이 다시 불러온 중독성 열풍
ITZY 대추 노노 열풍이 온라인에서 확산되며 그룹 ITZY의 무대가 다시 주목받고 있다. 최근 팬들 사이에…
관련 포스팅
Copyright blog.dowoo.me All right reserved.